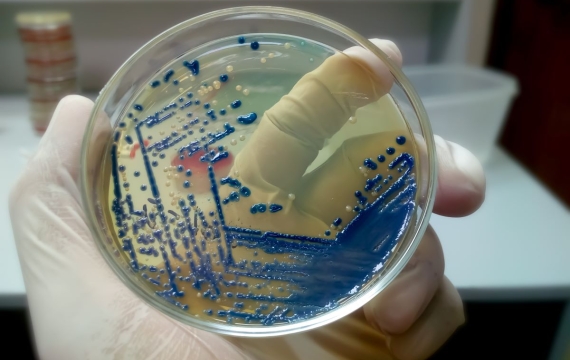
medios-de-cultivo

Anatomía patológica

Anatomía patológica en Valencia
La anatomía patológica es un área de la medicina que estudia las bases morfológicas de la enfermedad. El origen de la anatomía patológica es tan antiguo como la medicina, ya que se basa en la observación directa del órgano enfermo.

Anatomía patológica la ciencia detrás del diagnóstico médico
La anatomía patológica es una rama de la medicina que se enfoca en el estudio de las enfermedades y las alteraciones en los tejidos y órganos del cuerpo humano. Esta disciplina se encarga de analizar las muestras biológicas para determinar la presencia de patologías y establecer un diagnóstico preciso que permita brindar el tratamiento adecuado. En este artículo, exploraremos la importancia de la anatomía patológica en la medicina y cómo su uso puede ayudar a salvar vidas.

Esta rama de la medicina es una herramienta fundamental para la ciencia médica moderna, ya que permite el diagnóstico preciso de enfermedades y la evaluación de la respuesta al tratamiento. Esta disciplina se ocupa del estudio de las muestras de tejido, líquidos corporales y células, para determinar si presentan alguna anomalía o patología. Las técnicas de análisis incluyen la observación macroscópica y microscópica de las muestras, la utilización de tinciones especiales para identificar estructuras específicas y la aplicación de técnicas moleculares para detectar alteraciones genéticas.
Uno de los mayores beneficios de esta área de la anatomía es la capacidad de establecer un diagnóstico preciso y específico. El análisis de las muestras de tejido permite identificar la causa subyacente de los síntomas de un paciente y determinar el tratamiento más adecuado. Por ejemplo, en el caso del cáncer, la anatomía patológica puede identificar el tipo de célula afectada, la extensión de la enfermedad y el grado de agresividad, lo que permite al oncólogo seleccionar el tratamiento más adecuado para el paciente.

Aplicaciones en la medicina
La anatomía patológica juega un papel fundamental en el diagnóstico de cáncer. Los médicos utilizan la información obtenida por los anatomopatólogos para diagnosticar y determinar la etapa del cáncer, lo que a su vez determina el tipo de tratamiento necesario.
La biopsia es el procedimiento más habitual utilizado para obtener muestras de tejido para el examen anatomopatológico. El patólogo examina las muestras microscópicamente para determinar si las células son cancerosas o no. Si se diagnostica cáncer, el patólogo también determinará el tipo y la gravedad del cáncer.
Una vez que se ha realizado el diagnóstico, el médico puede determinar el mejor curso de acción para el paciente. Esto puede incluir cirugía, radioterapia, quimioterapia, terapias dirigidas o una combinación de estos tratamientos. La información proporcionada por la anatomía patológica es esencial para la selección del tratamiento adecuado y para la planificación del seguimiento del paciente.

Importancia en la investigación médica
Además de su papel en el diagnóstico y tratamiento del cáncer, la anatomía también es importante en la investigación médica. Los patólogos utilizan técnicas avanzadas de análisis de tejidos para comprender mejor los procesos de enfermedad y desarrollar nuevos tratamientos.
Los estudios de anatomía patológica permiten a los investigadores comprender mejor cómo las células cancerosas se comportan y cómo se propagan. También pueden identificar marcadores específicos que pueden utilizarse como objetivos para el tratamiento. Los avances en la investigación en anatomía patológica han llevado a mejoras significativas en el diagnóstico y tratamiento del cáncer, así como de otras enfermedades.